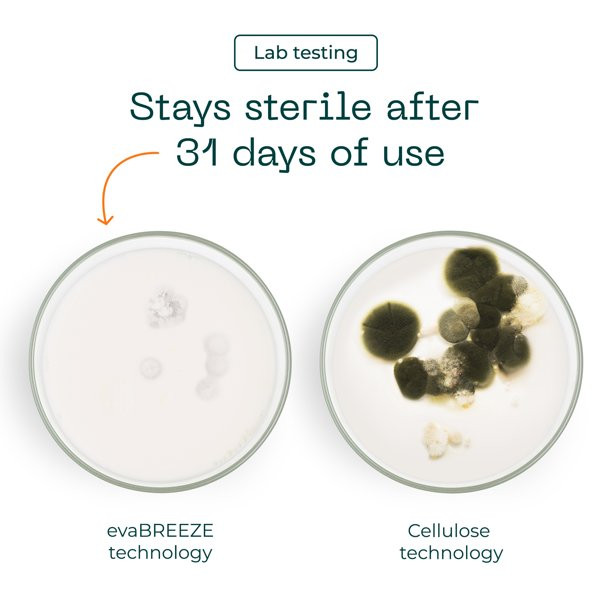

Home
/
1027
1027
Clear all


QUICK VIEW
Lego Star Wars Death Star Trash Compactor Diorama 75339 Building Kit For Adults. (802 Pieces)


QUICK VIEW
Evapolar evaCHILL Personal Evaporative Air Cooler and Humidifier. Mini Air Cooler 27 Oz. White


QUICK VIEW
Inse E3 Robot Vacuum With 2000Pa Strong Suction. Quiet. Slim Smart Robotic Vacuum Cleaner


QUICK VIEW